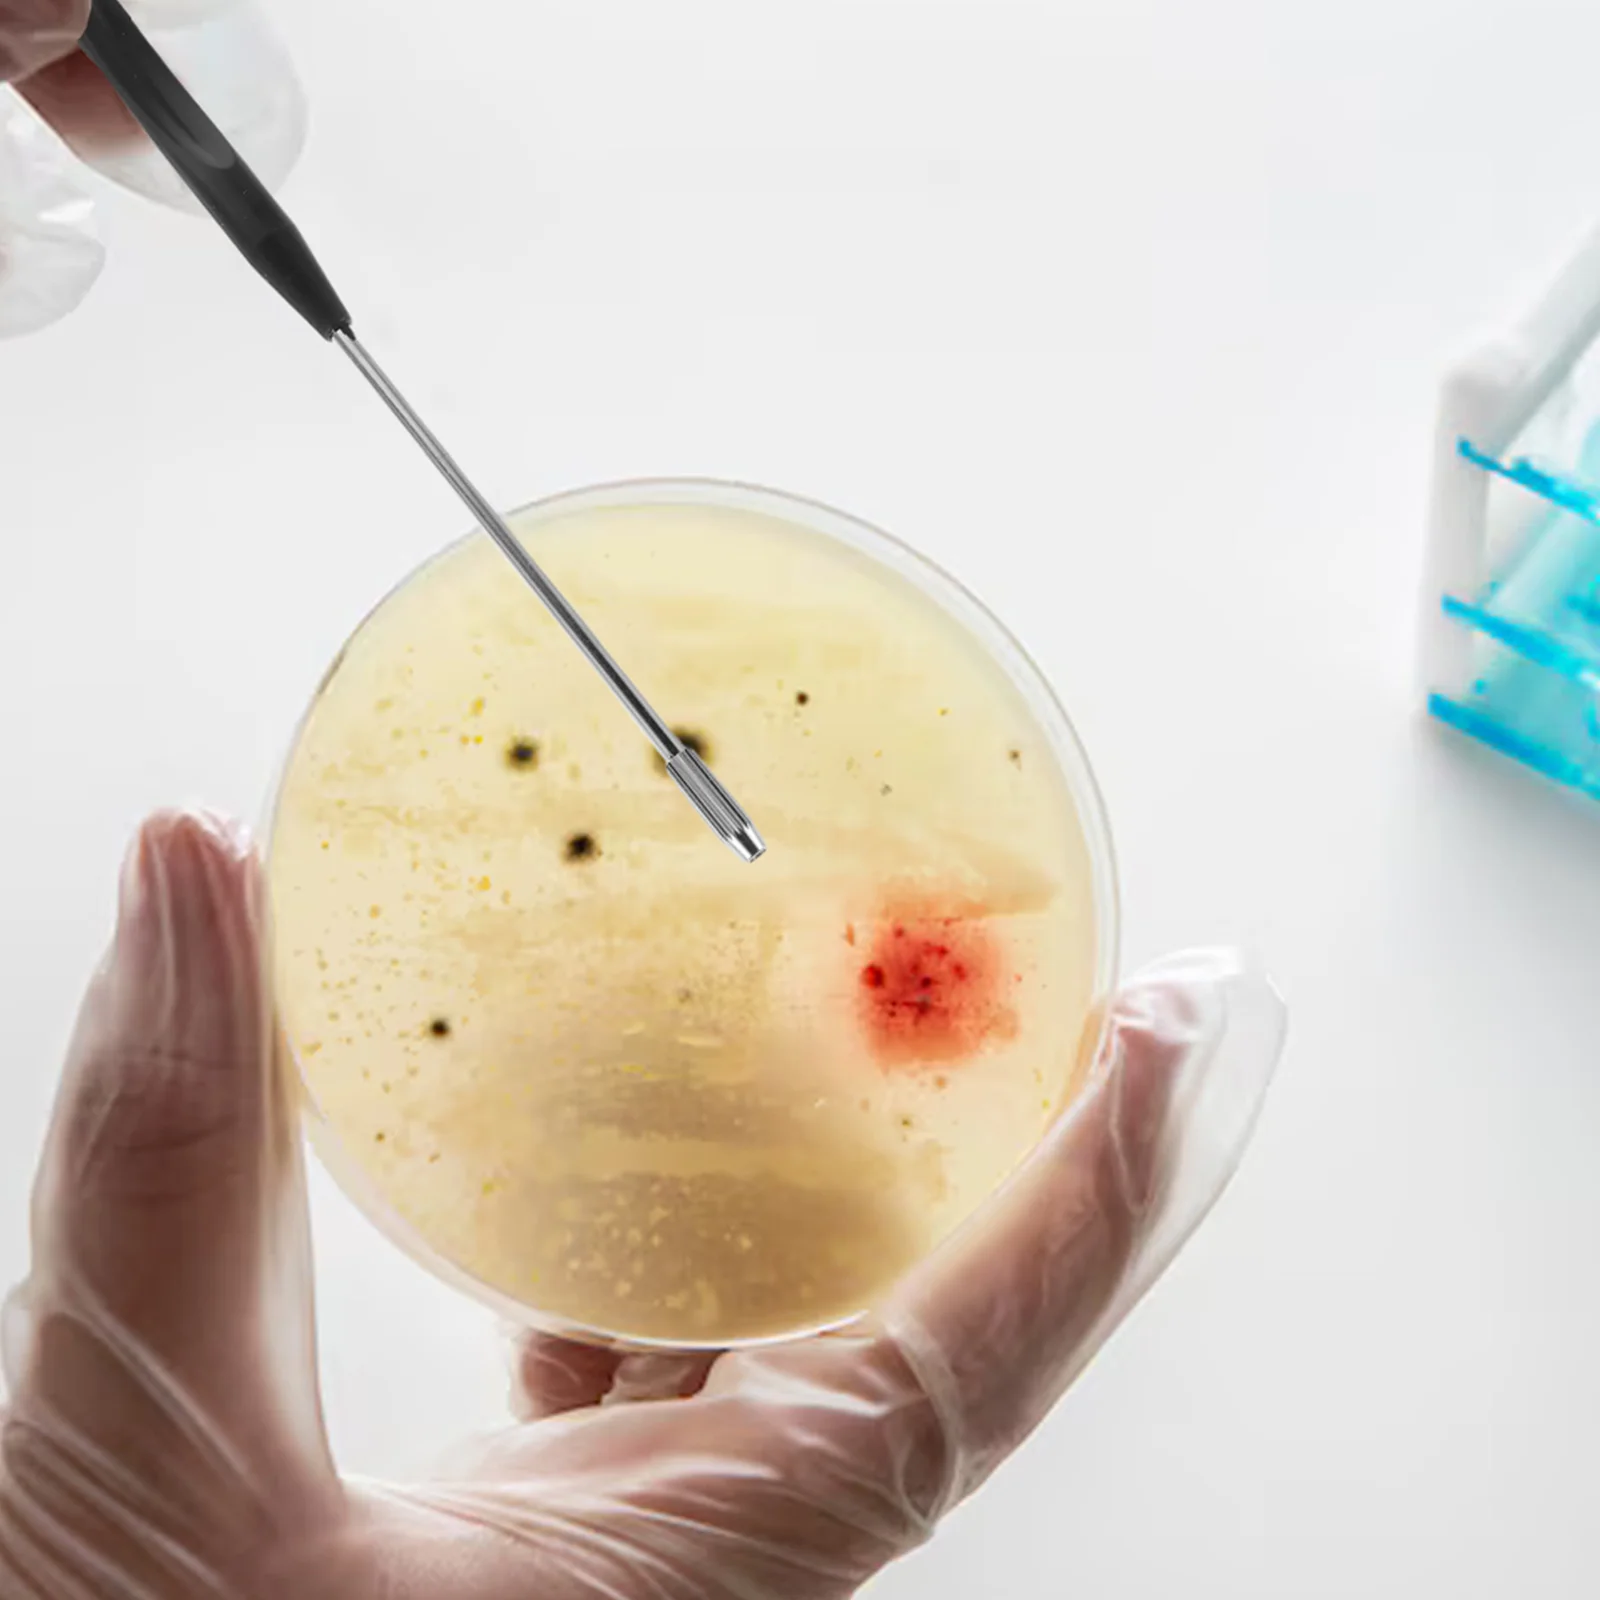
thumb

4 Pcs Sterile Inoculation Tools Rings Copper Probe Rod Dowsing Kit Inoculating Loops Rods Sticks
Price history chart & currency exchange rate
Customers also viewed

$2.37
Leg Replacement Support Parts Black Drum Set Leg Non Slip Stainless Steel Easy Install Long Life Drum Accessories
aliexpress.ru
$2.93
2pcs Crown Set Women Sash Rhinestone Decorations 40th Lace Straps Quality Durable Glitter Birthday Crown Sweet
aliexpress.ru
$2.07
12pcs LED Electronic Candles Smokeless Operated PP Material Durable Transparent Design Realistic Candlelight Warm
aliexpress.ru
$9.71
48 Pcs Ethnic Style Gift Bag Candy Drawstring Bags for Kids Storage Snack Present Cloth Vacation Packing
aliexpress.ru
$34.49
Male Casual Shoe Square Toe Men's Leather Shoes Pu New In Footwear Offer Social 2024 Trend Size 45 Classic Original Summer Sale
aliexpress.com
$178.80
Sliver Buckle Strap Hollow Sandals Metal Stiletto High Heel Matte Leather Fashion Sexy Women Shoes 2024 New Zapatos Para Mujere
aliexpress.com
$9.42
5m Guitar Effects Cable 6.35mm Audio Cable for AMP Sound Mixer Electronic Organ Guitar Bass Cable Shielded Parts & Accessories
aliexpress.com
$7.96
Игровой коврик для мыши Adventure time, большой коврик для мыши, большой коврик для мыши, компьютерный коврик для мыши, Настольный коврик для клавиатуры, подушка XXL XL
aliexpress.ru
$26.75
designer domino sneaker canvas casual shoes women men low skateboard shoe italy fashion canvas shoes trainer outdoor sport skate loafer brow
dhgate.com
$3.71
Светодиодные лампы для гаража в форме лопасти вентилятора, складные потолочные светильники для украшения гаража, запасные мини-светильник...
aliexpress.ru
$6.05
Shiny Clear CZ C-Shape Drop Earring for Women Real 925 Sterling Silver Simple Geometric Round Dangle Fine Jewelry 210707
dhgate.com
$615.96
newest 6 in 1 vacuum diode lipo laser slimming fat cavitation machine face lifting rf cavitation 80k
dhgate.com
$0.53
Neutral Pen Cartoon Creative Cute Students Use Stationery Test Prizes Fresh Office Supplies Needle Tube Signature Gift by sea RRB14798
dhgate.com
$21.37
Tcare Back Lumbar Support Belt Waist Orthopedic Corset Trainer Trimmer Unisex Workout Waist Decompression Back Brace Pain Relief
aliexpress.com
$5.70
Protable 7-Layer Metal Weed Box Removable Herb Case Good sealing waterpoof Pill Bottle Laser Carving With Key Chain Outdoor
aliexpress.ru
$19.20
2022 New youth Fashion High elastic straight jeans comfortable men's casual loose trousers trousers
aliexpress.com
$14.94
Женский венок весна-лето, венок для входной двери, окна на стену, свадьбу, вечеринку, сад, фермерский Декор для дома
aliexpress.com
$0.61
VODOOL Water Cooling Fittings G1/4 External Thread for 9.5X12.7mm Soft Tube PC Computer Water Cooling System Connector
aliexpress.com
$1.92
India Sexy Couple Nude Tapestry Woman Man Wall Hanging Hippie Bedroom Wall Decoration Room Dormitory Decor Art Aesthetics Tapiz
aliexpress.com
$1.40
For Xiaomi Mi Note 10 Pro Back Battery Cover CC9 Pro Rear Housing Glass Door for Xiaomi Mi Note 10 Pro Battery Cover+Camera Lens
aliexpress.com
$34.00
Мужские кожаные кроссовки, Повседневная Удобная Обувь на массивной подошве, дышащая нескользящая обувь с вулканизированной подошвой, весн...
aliexpress.ru
$30.86
2x 2inch abs сабвуфер коаксиальный динамик сетка решетки крышка нч серебряный динамик крышка гриль 56 мм автомобиль
dhgate.com
$30.82
16 Mitch Marner 2018 Stadium Series Toronto Maple Leafs Auston Matthews Tyler Bozak Zach Hyman Nazem Kadri Leo Komarov Josh Leivo Jerseys
dhgate.com
$11.04
Чехол-накладка iPaky для Xiaomi Mi Max 2 силиконовый со вставкой металлик (черный/серый)
teek.ru
$1.30
Коробка для колец с светодиодной подсветкой в форме сердца для хранения на годовщину свадьбы, День святого Валентина (красная) Коробка для колец со светодиодной подсветкой
aliexpress.ru
$13.73
Женский топ с кружевным ремешком Sweet d, Новое поступление лета, Dongda Gate, 2022, блузка с цветочным принтом Svel
aliexpress.ru
$5.43
Нескользящий H-образный безопасный поручень для детей пожилого возраста, подлокотник для ванной комнаты, высококачественная настенная H-рейка из нержавеющей стали для хранения
aliexpress.ru
$818.83
Литий-ионный аккумулятор 48 В, 80 Ач, 60 В, литиевая батарея BMS 13S 16S для 5000 Вт, 8000 Вт, скутера, велосипеда, трехколесного велосипеда, двигателя с зарядным устройством
aliexpress.ru
$103.30
Электромагнитный клапан отключения RP2310B 12 В подходит для дизельных двигателей
aliexpress.ru
$8.60
Оригинальный дизайн, мужской ожерелье, универсальный кулон в стиле хип-хоп, Fremen, модный бренд ex Nelace, мощная атмосфера
aliexpress.ru